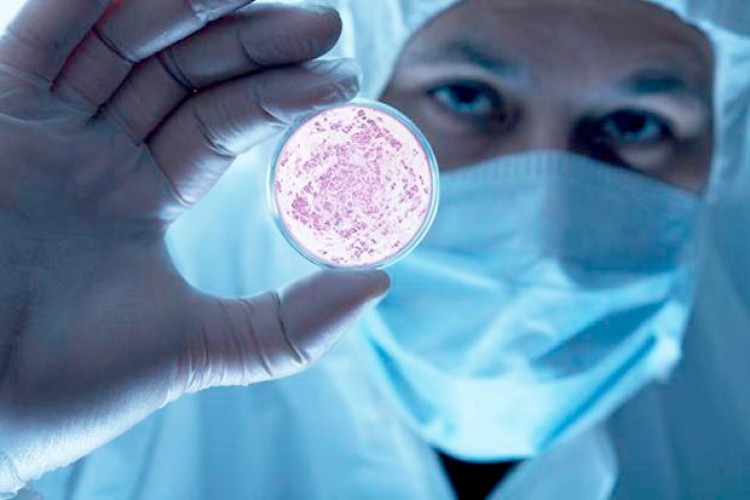

Los efectos del deshielo del permafrost para los modos de vida y los ecosistemas no son un misterio para nadie.Los habitantes de la península de Yamal, a 2.500 kilómetros al nordeste de Moscú, lo han sufrido en carne propia: un niño murió y otras 23 personas enfermaron en julio de carbunco (o ántrax). Hacía 75 años que la enfermedad había desaparecido de la región.Los científicos consideran que la reaparición se debe probablemente a la descongelación de un cadáver de reno muerto de ántrax hace décadas. Una vez liberada, la bacteria mortal (un bacilo) infectó a numerosas manadas de renos."¿Puede repetirse el proceso? Claro que sí", advirtió en una rueda de prensa reciente Boris Kerchengoltz, investigador del Instituto ruso sobre los problemas biológicos del permafrost.La temperatura en Rusia aumenta 2,5 veces más rápido en promedio que en el resto del mundo, y en el Ártico el cambio todavía es más veloz. Virus gigantes en los mamut En Yamal, península poblada sobre todo por ganaderos nómadas y situada entre el mar de Kara y el golfo del Obi, las temperaturas fueron 8 grados más altas de lo normal para julio, rondando los 35 grados."Estamos hablando de un lugar más allá del círculo polar", afirma Serguei Semenov, director del Instituto ruso del clima. "Es una anomalía sin precedentes". Para los científicos, la amenaza está lejos de limitarse al ántrax."Hay restos de viruela" en el Extremo Norte que se remontan al final del siglo XIX y los investigadores descubrieron "virus gigantes" en cadáveres de mamuts, actualmente estudiados, explicó Viktor Maléyev, director adjunto del Instituto de Investigación ruso de epidemiología."Creo que el cambio climático nos va a traer muchas sorpresas", advirtió. "No quiero asustar a nadie pero deberíamos estar preparados".Según este experto, la propagación de los casos de ántrax se habría podido contener mejor si los renos hubieran estado vacunados masivamente. Señal de alarmaDimitri Kobylkin, gobernador de la región Yamalo-Nenetski, donde este verano han muerto más de 2.000 renos, afirma que se dejó de vacunar a estos animales hace unos diez años, quizá porque se creía que el ántrax había desaparecido desde hacía tiempo. "Un error muy grave", reconoció.Según él, la zona afectada mide 12.650 km2. La desinfección continuará hasta que los análisis del suelo dejen de dar positivo al ántrax, aseguró el gobernador.Más de 1.500 personas han sido vacunadas y más de 700 que corren riesgo deben tomar antibióticos, según las autoridades locales. Alrededor de 270 soldados se encargan de incinerar los restos de los animales infectados.Se trata de un dispositivo sin precedentes en Rusia "tanto en escala como en complejidad", explicó el gobernador. "Nunca habíamos previsto una amenaza bacteriológica como ésta", reconoció.Los científicos lamentan que en lugar de invertir en investigación sobre el cambio climático, las autoridades recorten los presupuestos destinados a la ciencia y gasten sólo en atender las situaciones de emergencia.Valéri Malinin, oceanólogo del Instituto ruso de hidrometeorología, recuerda que en 2010 se puso en marcha un programa de investigación sobre el clima debido a la humareda sofocante que envolvió Moscú tras unos incendios… pero después "fue enterrado"."Cuando nos vemos frente a fenómenos destructivos, siempre pensamos que habría que haberlos evitado, pero en cuanto el ímpetu decae, nos olvidamos de todo", lamenta. "Yamal no es más que una señal de alarma: la naturaleza seguirá desafiándonos".Fuente: Agencia de Noticias AFP/NA
Los efectos del deshielo del permafrost para los modos de vida y los ecosistemas no son un misterio para nadie.Los habitantes de la península de Yamal, a 2.500 kilómetros al nordeste de Moscú, lo han sufrido en carne propia: un niño murió y otras 23 personas enfermaron en julio de carbunco (o ántrax). Hacía 75 años que la enfermedad había desaparecido de la región.Los científicos consideran que la reaparición se debe probablemente a la descongelación de un cadáver de reno muerto de ántrax hace décadas. Una vez liberada, la bacteria mortal (un bacilo) infectó a numerosas manadas de renos."¿Puede repetirse el proceso? Claro que sí", advirtió en una rueda de prensa reciente Boris Kerchengoltz, investigador del Instituto ruso sobre los problemas biológicos del permafrost.La temperatura en Rusia aumenta 2,5 veces más rápido en promedio que en el resto del mundo, y en el Ártico el cambio todavía es más veloz. Virus gigantes en los mamut En Yamal, península poblada sobre todo por ganaderos nómadas y situada entre el mar de Kara y el golfo del Obi, las temperaturas fueron 8 grados más altas de lo normal para julio, rondando los 35 grados."Estamos hablando de un lugar más allá del círculo polar", afirma Serguei Semenov, director del Instituto ruso del clima. "Es una anomalía sin precedentes". Para los científicos, la amenaza está lejos de limitarse al ántrax."Hay restos de viruela" en el Extremo Norte que se remontan al final del siglo XIX y los investigadores descubrieron "virus gigantes" en cadáveres de mamuts, actualmente estudiados, explicó Viktor Maléyev, director adjunto del Instituto de Investigación ruso de epidemiología."Creo que el cambio climático nos va a traer muchas sorpresas", advirtió. "No quiero asustar a nadie pero deberíamos estar preparados".Según este experto, la propagación de los casos de ántrax se habría podido contener mejor si los renos hubieran estado vacunados masivamente. Señal de alarmaDimitri Kobylkin, gobernador de la región Yamalo-Nenetski, donde este verano han muerto más de 2.000 renos, afirma que se dejó de vacunar a estos animales hace unos diez años, quizá porque se creía que el ántrax había desaparecido desde hacía tiempo. "Un error muy grave", reconoció.Según él, la zona afectada mide 12.650 km2. La desinfección continuará hasta que los análisis del suelo dejen de dar positivo al ántrax, aseguró el gobernador.Más de 1.500 personas han sido vacunadas y más de 700 que corren riesgo deben tomar antibióticos, según las autoridades locales. Alrededor de 270 soldados se encargan de incinerar los restos de los animales infectados.Se trata de un dispositivo sin precedentes en Rusia "tanto en escala como en complejidad", explicó el gobernador. "Nunca habíamos previsto una amenaza bacteriológica como ésta", reconoció.Los científicos lamentan que en lugar de invertir en investigación sobre el cambio climático, las autoridades recorten los presupuestos destinados a la ciencia y gasten sólo en atender las situaciones de emergencia.Valéri Malinin, oceanólogo del Instituto ruso de hidrometeorología, recuerda que en 2010 se puso en marcha un programa de investigación sobre el clima debido a la humareda sofocante que envolvió Moscú tras unos incendios… pero después "fue enterrado"."Cuando nos vemos frente a fenómenos destructivos, siempre pensamos que habría que haberlos evitado, pero en cuanto el ímpetu decae, nos olvidamos de todo", lamenta. "Yamal no es más que una señal de alarma: la naturaleza seguirá desafiándonos".Fuente: Agencia de Noticias AFP/NA







Discussion about this post